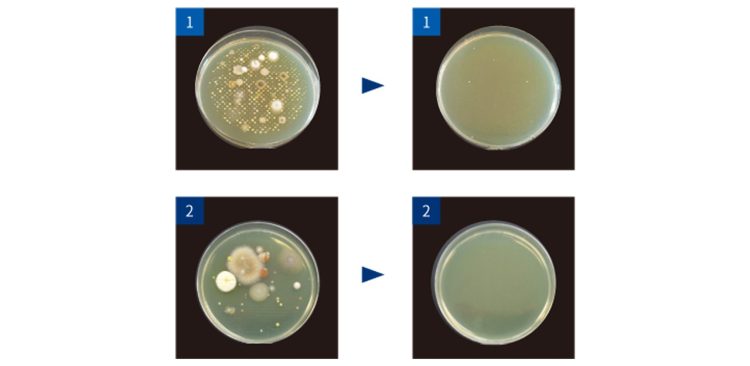

NEWS
空間除菌 エアロシールド
2022.06.01
空気環境対策に、新しいご提案
紫外線は波長によりUV-A・UV-B・UV-Cの3種類に分類され、その効果も異なります。
「エアロシールド」は高い浮遊菌・ウイルス減少効果を持つ「UV-C」ランプを使用しております。
UV-Cの波長は「耐性菌をつくらない(※)」「常温で利用可能」など、紫外線照射効果の優れた特性があります。
※紫外線に対する抵抗力を持った菌
「エアロシールド」は高い浮遊菌・ウイルス減少効果を持つ「UV-C」ランプを使用しております。
UV-Cの波長は「耐性菌をつくらない(※)」「常温で利用可能」など、紫外線照射効果の優れた特性があります。
※紫外線に対する抵抗力を持った菌
特徴
人がいる空間でも安全に紫外線照射
「エアロシールド」は特殊なルーバー(仕切り板)構造による紫外線の水平照射を実現しており、天井付近に紫外線ゾーンを形成します。
人が生活する空間に影響を及ぼすことなく24時間使用できます。
また設置やメンテナンスの際にはJIS規格に基づいた適正な基準を設け、紫外線を測定し安全管理を徹底しております。
人が生活する空間に影響を及ぼすことなく24時間使用できます。
また設置やメンテナンスの際にはJIS規格に基づいた適正な基準を設け、紫外線を測定し安全管理を徹底しております。
CDC(米国疾病対策センター)は、WHO(世界保険機関)とともに世界の感染症に対応する専門機関です。
「エアロシールド」が採用しているUV-C(紫外線C波)を利用した空気清浄法はCDCが発行する「医療機関における結核菌伝播予防のためのガイドライン」で「UVGI」として掲載されています。
「エアロシールド」が採用しているUV-C(紫外線C波)を利用した空気清浄法はCDCが発行する「医療機関における結核菌伝播予防のためのガイドライン」で「UVGI」として掲載されています。
本製品は社団法人日本工業技術振興協会の技術評価情報センター(CTA)による技術評価を受けており、「競合他種の装置に比較してきわめて大きな優位性を発揮するのもと考えられる。」という評価を頂いております。
メーカー独自技術による安全な紫外線(UV-C)ゾーンの形成
実証試験で浮遊菌減少の結果が得られています
「エアロシールド」は第三者研究機関の実証試験により、「実空間における浮遊菌減少が89.6%」と結果を得ています。
この試験は試験用ボックスではなく実際に人が生活する広さの空間で行なわれており、実用性も証明されています。
また、医療機関をはじめ様々なお客様の施設においても実証試験を行い、同様の浮遊菌減少の結果が得られています。
この試験は試験用ボックスではなく実際に人が生活する広さの空間で行なわれており、実用性も証明されています。
また、医療機関をはじめ様々なお客様の施設においても実証試験を行い、同様の浮遊菌減少の結果が得られています。

臨床実験施設での浮遊菌減少試験
【検査機関】株式会社ビー・エム・エル
【検査内容】エアロシールドUKP18浮遊細菌効果テスト
【検査報告書発行日】平成22年6月11日
* 報告書書類2頁:エアロシールドUKP18(BML総合研究所ビジターズルーム2)浮遊菌数検査結果 平成22年5月31日 の数値に基づく値/数値は1m³中に換算した浮遊菌数(cfu)
【検査内容】エアロシールドUKP18浮遊細菌効果テスト
【検査報告書発行日】平成22年6月11日
* 報告書書類2頁:エアロシールドUKP18(BML総合研究所ビジターズルーム2)浮遊菌数検査結果 平成22年5月31日 の数値に基づく値/数値は1m³中に換算した浮遊菌数(cfu)
導入施設における実空間での結果
大分大学工学部応用化学科監修の元、調査・エアーサンプラーを導入施設で使用して、浮遊菌を捕集・培養した結果
1 導入医療施設の実空間における検査結果/平成23年4月20日実施
(左:4月20日18時05分・右:4月21日10時05分)
2 導入保育施設の実空間における検査結果/平成26年10月18日実施
(左:10月18日9時30分・右:10月20日9時)
1 導入医療施設の実空間における検査結果/平成23年4月20日実施
(左:4月20日18時05分・右:4月21日10時05分)
2 導入保育施設の実空間における検査結果/平成26年10月18日実施
(左:10月18日9時30分・右:10月20日9時)
仕様
| 設置方法 | 壁面・天井 |
|---|---|
| 照射方法 | 紫外線水平照射方式 |
| 設置目安 | 【UKP09】立米:20〜50㎥ 平米:8〜20㎡ 【UKP18】立米:50〜120㎥ 平米:20〜40㎡ |
| ランプ | 【UKP09】UVC 9W 【UKP18】UVC 18W |
| 消費電力 | 【UKP09】13W 【UKP18】20W |
| 電源 | 500 (W)×405 (H)×550 (D)mm(突起物含まず) |
| 外寸法 | W280×D125×H115mm |
| 重量 | 約3Kg |
本件に関するお問い合わせはこちらから
























